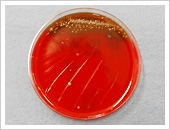

根管治療
根管治療とは
根管治療とは、細菌に感染したり損傷を受けた歯髄を取り除くことによって歯根周辺の病気を治療するものです。
深いむし歯や歯の亀裂、歯への外傷によって歯髄が細菌に感染したり、損傷したり、歯髄死になることもあります。
そのまま放っておくと、歯根周辺の組織にも感染が広がり、痛みや腫れが生じます。
治療しないと抜歯が必要になるケースもあるため、早期に治療を行うことが重要です。
深いむし歯や歯の亀裂、歯への外傷によって歯髄が細菌に感染したり、損傷したり、歯髄死になることもあります。
そのまま放っておくと、歯根周辺の組織にも感染が広がり、痛みや腫れが生じます。
治療しないと抜歯が必要になるケースもあるため、早期に治療を行うことが重要です。

1. 深いむし歯によって、歯髄が細菌に感染した歯。

2. むし歯部分を除去し、歯冠から歯髄腔まで穴をあけます。

3. ファイルという器具を用いて、歯髄腔および根管と感染された象牙質等をていねいに除去します。

4. 歯髄腔および根管を生物学的親和性をする素材で充填します。
根管治療の流れ
当院では根管治療時に、ほとんどの場合ラバーダムという歯のマスクを行います(写真1)これは患歯を孤立させることによって唾液の侵入を防ぎ、無菌的な操作を可能とします。
また、根管の無菌を確認するために、チェアーサイド嫌気培養システムを用いています。
血液寒天培地を使用して根の中のバイ菌が残っているかどうかという判定を行うものです。
根管内にバイ菌が残っている場合は、バイ菌はコロニーとなって出現します(写真2)が、きれいになっている場合にはバイ菌は出現しません(写真3)。
コロニーの数が非常に多い場合は、抗生物質の感受性テストを行って(写真4)バイ菌に対して有効な薬を選択します。
そして、きれいな状態になってから神経のかわりの材料を根の中につめます。
この治療法は、「こうして無菌の根管をつくった」というタイトルで永末書店から出版されています。
当院院長もその中で分担執筆をしています。

【写真1】
【写真2】

【写真3】

【写真4】